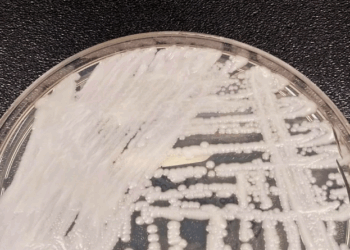
Fiocruz e Pasteur vão pesquisar sobre danos dos fungos no ser humano

Pesquisa revela que 52% dos brasileiros não fazem atividades físicas
Estudo indica que problemas de saúde quase dobram entre sedentários A Pesquisa Saúde e Trabalho, feita pelo Serviço Social da...
Leia MaisDetailsSaúde destina R$ 200 milhões para serviços de hemodiálise no SUS
Tratamento é indicado para pacientes com insuficiência renal Portaria do Ministério da Saúde publicada nesta segunda-feira (26) no Diário Oficial...
Leia MaisDetailsCárie está entre as doenças bucais mais comuns no Brasil
Os problemas bucais podem ter impacto na saúde de maneira geral. No Brasil, a cárie está entre as doenças bucais...
Leia MaisDetailsGoverno antecipa entrega de 400 mil doses de insulina de ação rápida
Distribuição no sistema de saúde ocorrerá até o dia 9 de julho Até o próximo dia 9, o Ministério da...
Leia MaisDetailsMinistério da Saúde quer ampliar digitalização e conectividade no SUS
Programa SUS Digital Brasil vai reforçar iniciativa Ampliar a digitalização no Sistema Único de Saúde (SUS) para incluir cada vez...
Leia MaisDetailsInverno exige hidratação para manter a pele saudável, recomenda dermatologista
Dermatologista destaca que beber bastante água e usar hidratante é importante para evitar ressecamento da pele O inverno chegou e...
Leia MaisDetailsDia de conscientização busca informar população sobre o lábio leporino
Malformação afeta uma criança em cada 650 nascimentos O universitário Alber Costa nasceu com fissura labiopalatina, uma malformação congênita caracterizada...
Leia MaisDetailsGenética e inflamação na gravidez explicam lábio leporino
Estudo mostra relação entre a causa genética e a ambiental Estudo realizado em animais conseguiu demonstrar, pela primeira vez, como a...
Leia MaisDetailsFiocruz e Pasteur vão pesquisar sobre danos dos fungos no ser humano
Unidade do instituto francês será instalada no Paraná A Fundação Oswaldo Cruz (Fiocruz) e o Instituto Pasteur firmaram parceria para...
Leia MaisDetailsEstudo revela melhoria da saúde mental ao parar de fumar
Pesquisa internacional descobre que interromper o tabagismo pode trazer benefícios para a saúde mental, especialmente em casos de ansiedade e...
Leia MaisDetailsBusca por Categorias
- Agro
- Agro
- Amanda Vidal
- Ana Karina Wiermann
- Artigo
- Assistência Social
- Cel Júlio Cezar Costa
- Cidades
- Cleilton Gomes Filho
- Colunas
- Conjuntura Politica
- Crônicas do Coronel
- Cultura
- Destaques
- Dr Eliezer Siqueira
- Dr Gustavo Peixoto
- Economia
- Educação
- Elimar Leal
- Entretenimento
- Esportes
- Fernando Capez
- Fernando Zambom
- Games
- Geral
- Geral
- Governo
- Internacional
- Jair Oliveira
- Justiça
- Karina Uchôa
- Laudiceia Veloso
- Ministro Augusto Nardes
- Mundo
- Nas ondas do rádio
- No ângulo
- Nutri em Ação
- O foco é educação
- Outros
- Pedro Ivo de Sousa
- Polícia
- Política
- Prega fogo e larga brasa
- Religião
- Saúde
- Saúde Emocional
- Sebastião Demuner
- Segurança
- Seus Direitos
- Social
- Social
- Steleijanes Carvalho
- Tecnologia
- Tecnologia
- Trabalho
- Turismo
- Um Aparte
- Wesley Neves
Notícias Recentes
Copyright © 2025 Vozes Comunicações - Todos os direitos reservados.